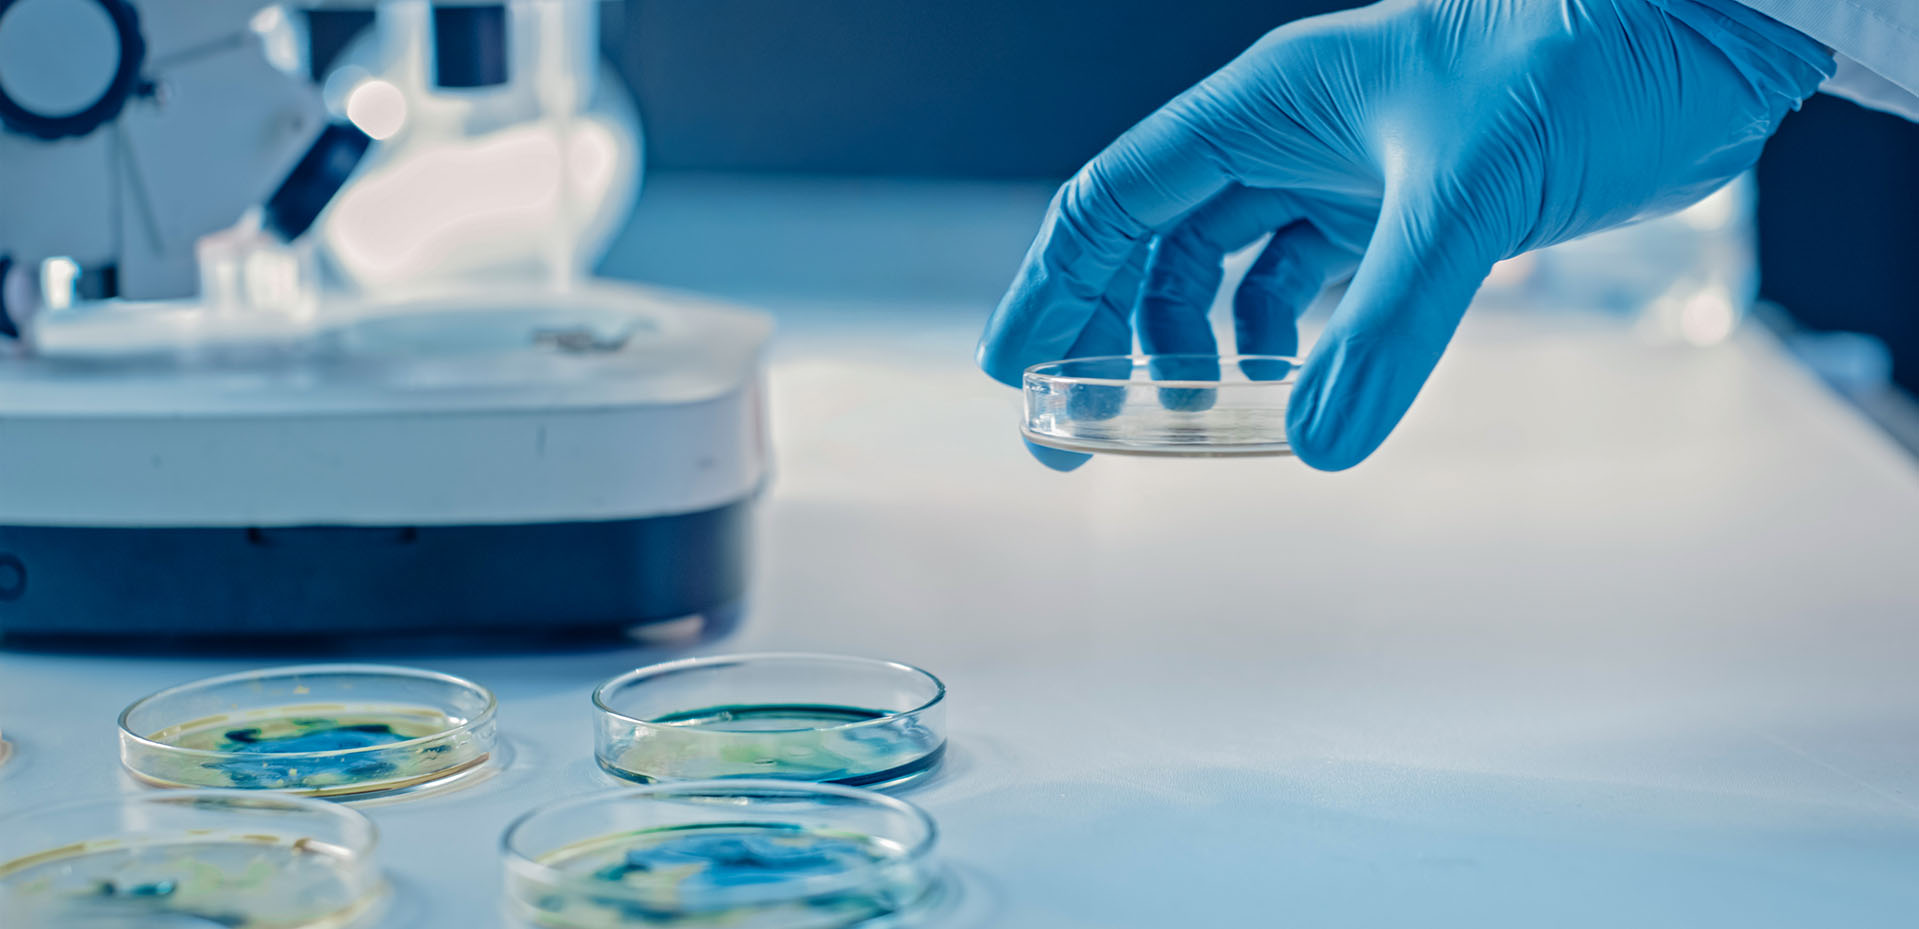
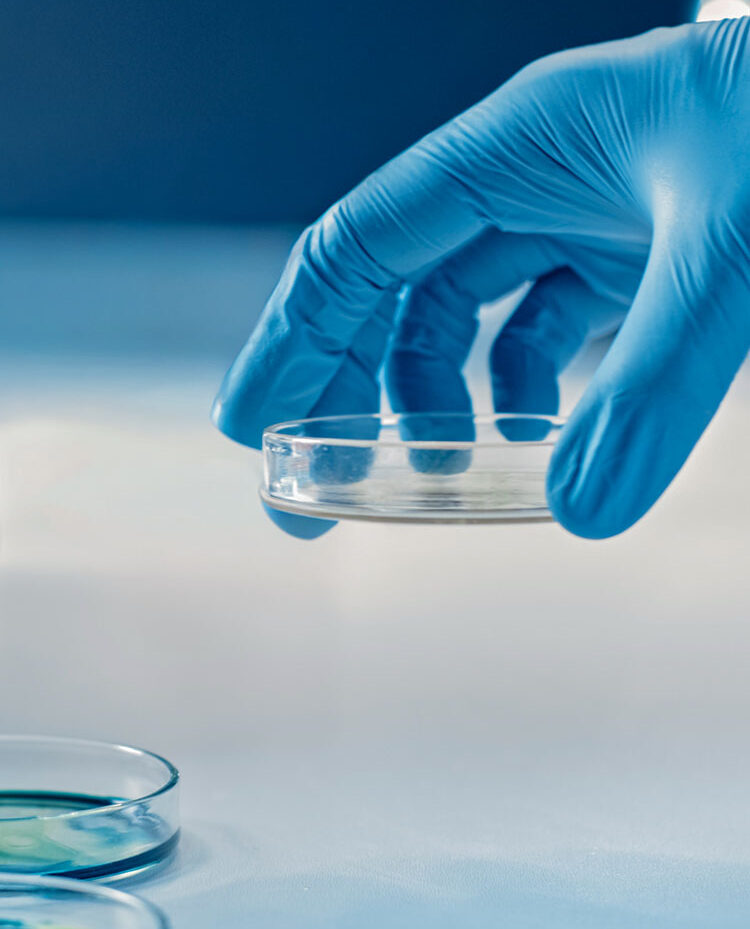

F2D Medical s’inscrit au cœur du parcours de soins en intégrant la médecine prédictive pour anticiper les besoins de santé de demain.
Premier dispositif médical non-invasif
de surveillance continue de la
température corporelle centrale
Bénéfices médicaux
- Aide au diagnostic précoce des infections et du sepsis
- Contextualisation des données pour une médecine personnalisée
- Traçabilité et intégration au dossier médical partagé (DPI)
Gain de productivité
- Brassard posé pour 24h vs prise de température toutes les 2 à 6h
- Suivi thérapeutique simplifié et sécurisé
Monitoring hôpital et HAD
- Suivi post-chimiothérapie
- Réanimation et soins intensifs
- Surveillance post-opératoire et suivi antibiothérapies
Prédiction fiable des algorithmes
Prise de température en continu
Mobilité & continuité des soins garantis
Thermodiag©
Une attente forte de monitoring de la température
Quelques chiffres
2021
Thermodiag utilisé quotidiennement en milieu hospitalier
Plus de 25 000 heures
d’acquisition de données
Algorithme opérationnel
validé sur l’adulte
5 phases cliniques
réalisées sur 5 cohortes, 466 sujets
(Clinical trials : NCT04311268)
Juin 2024
Certification ISO13485 délivrée

Notre engagement RSE
F2D Medical s’engage dans une démarche RSE en collaboration avec ses fournisseurs autour de 4 piliers :
- Qualité et sécurité : garantir les bonnes pratiques
- Engagement environnemental : minimiser notre impact écologique
- Innovation et digitalisation : faire émerger de nouvelles pratiques
- Impact local et communautaire : faire rayonner notre territoire

Notre board scientifique
Expertise, exigence, engagement.
Chez F2D Medical, nous sommes convaincus que l’innovation n’a de sens que si elle est utile sur le terrain. Notre board scientifique accompagne le développement de nos solutions lors de différentes étapes en veillant à leur pertinence clinique, leur fiabilité scientifique et leur impact pour les soignants et les patients. Médecins, chercheurs et professionnels de santé y partagent un objectif commun : faire émerger de nouvelles pratiques au regard des problématiques actuelles et à venir.
Où nous trouver ?

France

F2D Médical et Luquet & Duranton
Luquet & Duranton, fondée en 1898, est une société française spécialisée dans la conception et la fabrication d’imprimés techniques destinés au secteur hospitalier et administratif. Elle s’est progressivement diversifiée vers des solutions de traçabilité et d’identitovigilance, ainsi que vers des outils numériques innovants pour la gestion et la sécurisation du parcours patient.
Arabie Saoudite, Emirats Arabes Unis et Inde

F2D Médical et Datavitalis
Spécialisé dans l’introduction de nouvelles pratiques de soin et le lancement de dispositifs médicaux innovants, Datavitalis se concentre sur l’amélioration des soins préventifs et prédictifs. En tant que partenaire stratégique, l’entreprise assure la promotion, l’intégration et le support technique de Thermodiag sur ces marchés.
Nos dernières actualités

F2D Medical et Luquet & Duranton à la RICAI 2025

Thermodiag se déploie en France et à l’international : pourquoi lancer des pilotes cliniques ?
Nous contacter
Demande d’informations techniques ? Commerciales ?
Restez informé…
Suivez l’actualité de F2d Medical : l’entreprise, nos produits, les pratiques sur le terrain, nos innovations en santé…



